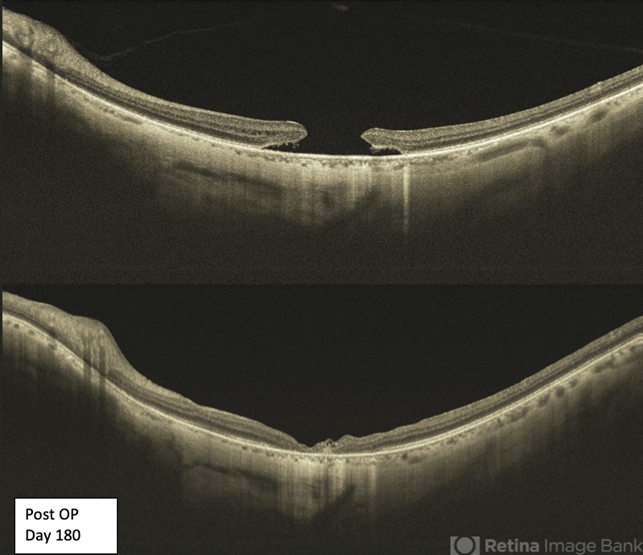

-
 By Thirumalesh Mochi Basavaraj, MD
By Thirumalesh Mochi Basavaraj, MD
Narayana Nethralaya - Uploaded on Jan 4, 2022.
- Last modified by Jennifer Carstens on Jan 11, 2022.
- Rating
- Appears in
- Miscellaneous
- Condition/keywords
- macular hole
- Photographer
- Puttaswamy Narayana Nethralaya
- Imaging device
-
Optical coherence tomography system
Topcon Dri Triton - Description
- Swept source OCT of a 65-yea-old patient with a large macular hole before and after surgery.

Initializing download.
Initializing download.










